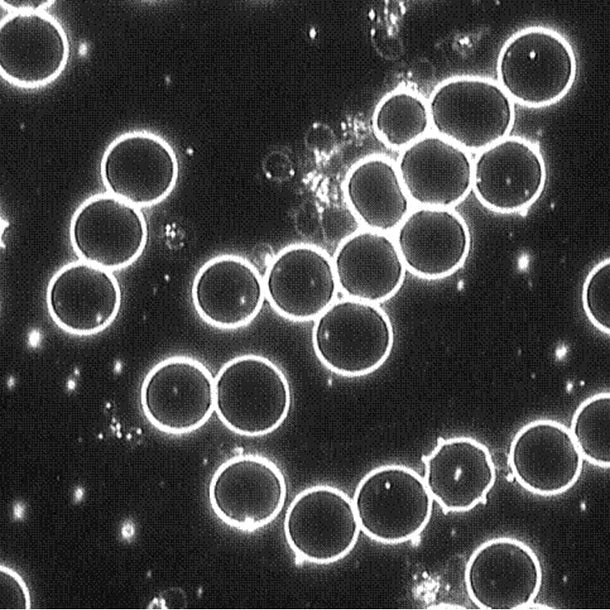

High Dose Ozone Therapy
What If You Could Remove Underlying Causes of Disease?
Oxygen detoxification treatments can benefit many for the treatment of Mold, Lyme’s Disease, Herpes, Hepatitis C & A, Diabetes Type I & II, Staph infection, HPV, Neuropathy, Strokes, Cysts and other chronic health conditions.
The average person’s lack of Oxygen and Minerals, especially natural organic Sulfur, has shown to be exactly why everybody’s blood looks like the black blood in the bag on the bottom right, instead of the oxygenated clean blood above it.

ALL PATHOGENS DIE IN THE PRESENCE OF OXYGEN
When active oxygen is infused directly into the blood, the Bio Rejuvenation benefits can be extremely rapid for a wide variety of ozone’s expected beneficial effects including: immune modulation, cardiovascular improvement, pathogenic microbe and toxin elimination, anti-inflammatory effects and cosmetic improvements. Many patients who undergo therapy will begin to feel the effects of High Dose Ozone benefits during their first session.

Unhealthy Clumped Cells
BEFORE Ozone Therapy

Healthy Cells with Inflammation
(white lines in background)
2 HOURS AFTER Ozone
Healthy Cells
The DAY AFTER Ozone Therapy